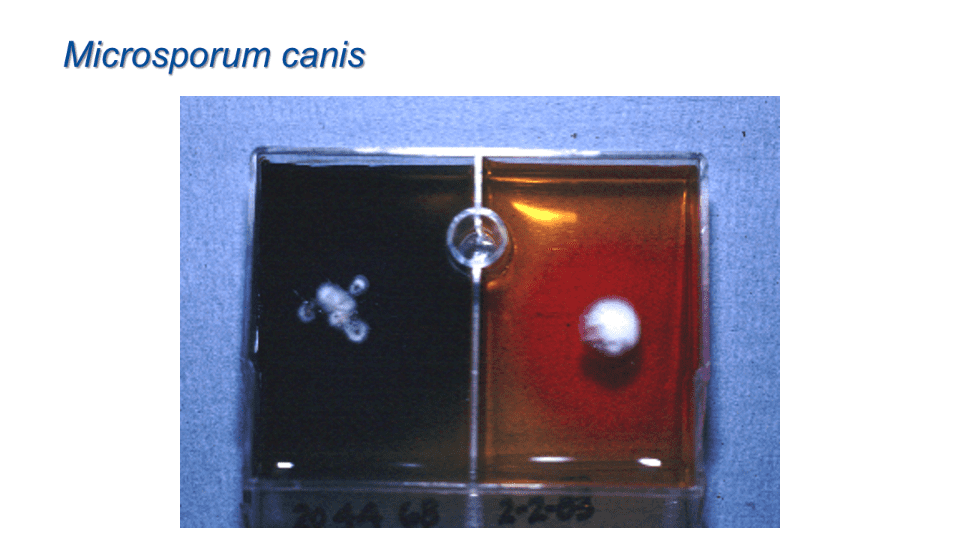
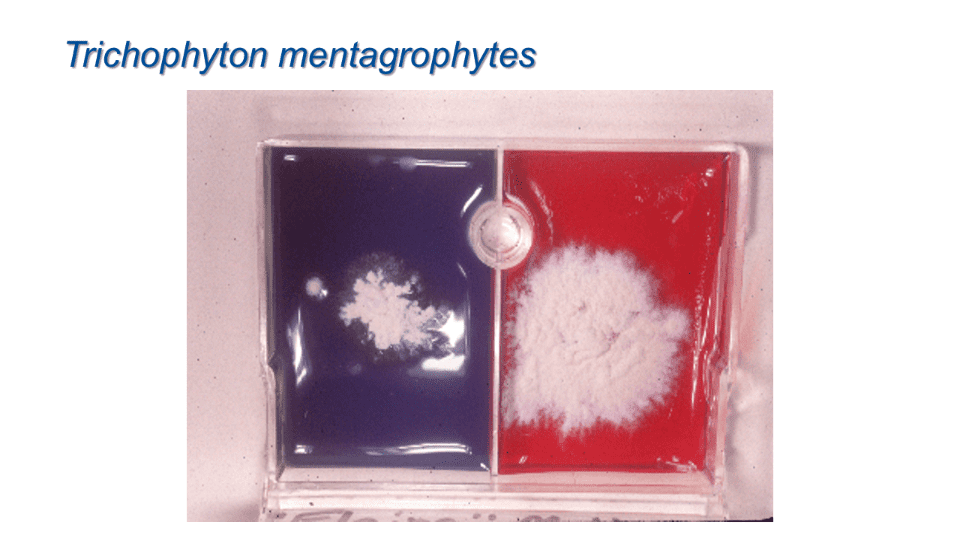

Diagnostic Techniques in Veterinary Dermatology
-

p.1 p.1
Diagnostic Techniques in
Veterinary DermatologyCandace A. Sousa, DVM
Diplomate (Emeritus) American Board of Veterinary Practitioners,
Canine and Feline Practice
Diplomate (Emeritus) American College of Veterinary Dermatologyp.1 -

p.2 p.2
In-Clinic Dermatology Tests
Dermatology is easy as there are only 9 tests that we do
- 8 1?2 can be done by technicians, and we only need 2 power tools!
1. Skin scraping
? Superficial for S. scabiei, Notoedres, D. gatoi
? Deep for Demodex spp
2. Acetate tape preparation
? Cheyletiella
? Licep.2 -

p.3 p.3
In-Clinic Dermatology Tests
3. Cytologic examination
? Pustule
? Surface debris
? Ears4. Wood’s lamp examination
? M. canis; hairs5. Fungal culture (DTM)
6. Bacterial culture +/- susceptibility
7. Skin biopsy
p.3 -

p.4 p.4
In-Clinic Dermatology Tests
8. Intradermal test or allergen-specific IgE serology
? Fleas only
? Complete panel9. Trichogram
? Blunted or chewed hairs
? Color dilute dogs
? Dermatophytes (?)
• CBC / chemistry profile (including T4) / UA / fecalp.4 -

p.5 p.5
Make a “Derm Box” for each exam room, treatment area and
include:
• No. 10 dull scalpel blades
• Spatula
• Mineral oil
• Flea comb
• Glass slides
• Double-sided tape
• Cotton swabs
• 25 gauge needles
• Culturettes
• Caliper/ rulerp.5 -

p.6 p.6
Skin Scraping
• Demodex canis
• Sarcoptes scabiei
• Notoedres cati
• Cheyletiella sp
• Otherp.6 -

p.7 p.7
1. Skin Scraping
• Superficial for S. scabiei, Notoedres, D. gatoi
• Deep for Demodex spp• All dogs and cats with alopecia
• All dogs and cats with comedones
• All dogs and cats with crusts
• All dogs and cats prior to the use of corticosteroidsp.7 -

p.8 p.8
If necessary, clip the hair
p.8 -

p.9 p.9
Slide, mineral oil, #10 scalpel blade
p.9 -

p.10 p.10
Touch the blade to the oil
p.10 -

p.11 p.11
Pinch the skin
p.11 -

p.12 p.12
For demodicosis, capillary oozing
p.12 -

p.13 p.13
For scabies, sample the stratum corneum
p.13 -

p.14 p.14
For scabies, sample the stratum corneum
p.14 -

p.15 p.15
Wipe the material onto the slide
p.15 -

p.16 p.16
2. Acetate tape to collect “bugs”
• Cheyletiella
• Licep.16 -

p.17 p.17
Use of clear acetate tape to collect parasites
p.17 -

p.18 p.18
3. Cutaneous Cytology
• Should be performed in almost every case
? Pustule
? Surface debris
? Ears
? Draining tracts
• Identification of bacteria and yeastp.18 -

p.19 p.19
Cutaneous Cytology
• Various collection methods
? Direct touch prep
? Spatula
? Cotton-tipped swab
? Clear acetate tape
? Sticky slides
– DuraTak
– Double-sided tapep.19 -

p.20 p.20
Rub the slide on the skin
p.20 -

p.21 p.21
Even between the digits
p.21 -

p.22 p.22
Or the bottom of the foot
p.22 -

p.23 p.23
Sample the ear canal with a cotton - tipped swab
p.23 -

p.24 p.24
DiffQuick stain (no need to heat fix)
p.24 -

p.25 p.25
Malassezia pachydermatis (OIF)
p.25 -

p.26 p.26
Otic cytology
100X 100X
Bacteria - Cocci Bacteria - Rodsp.26 -

p.27 p.27
Cytology of pustule – neutrophils, intracellular cocci
p.27 -

p.28 p.28
Pemphigus foliaceus
p.28 -

p.29 p.29
Acantholytic cells – pemphigus
10X
Tzank prepp.29 -

p.30 p.30
4. Wood’s lamp / Ultraviolet light
p.30 -

p.31 p.31
4. Wood’s lamp / Ultraviolet light
p.31 -

p.32 p.32
Fluorescent positive hairs, M. canis
p.32 -

p.33 p.33
5. Fungal Culture
• Gently wipe or cleanse
• Collect fine scales and broken hairs
? Those that fluoresce
? Sterile toothbrush, about 30 strokes
• Material pressed onto, not into, the agar
• Room temperature or warmer
• Needs air
• Examine dailyp.33 -

p.34 p.34
Pluck fluorescent positive hairs
p.34 -

p.35 p.35
Scrape broken hairs and scales
p.35 -

p.36 p.36
Sterile / clean toothbrushes
p.36 -

p.37 p.37
Brush non - lesional animals, 5 minutes
p.37 -

p.38 p.38
Fungal culture
• RED COLOR CHANGE WITH THE FIRST SIGN OF COLONY GROWTH
• Colonies are white or cream-colored
• Dermatophytes usually grow within 10 days
• Keep cultures for 21 daysp.38 -

p.39 p.39
Derm - Duet; color change with the first sign of colony growth
p.39 -

p.40 p.40
Dermatophytosis – Diagnosis
Saprophyte (contaminant)p.40 -
p.41 p.41
Microsporum canis
p.41 -
p.42 p.42
Trichophyton mentagrophytes
p.42 -

p.43 p.43
Identification of the colony
• Wet mount or acetate tape preparation
• Lactophenol cotton blue, new methylene blue or blue from the Diff- Quik stainp.43 -

p.44 p.44
Clear acetate tape
p.44 -

p.45 p.45
Tape attached to a stick
p.45 -

p.46 p.46
Ribbon of new methylene blue
p.46 -

p.47 p.47
Collecting spores on the tape
p.47 -

p.48 p.48
Place the tape on the stain
p.48 -

p.49 p.49
Microsporum canis , macroconidia
p.49 -

p.50 p.50
Microsporum canis , macroconidia
p.50 -

p.51 p.51
Microsporum canis , macroconidia
More than 6 divisionsp.51 -

p.52 p.52
Trichophyton mentagrophytes , microconidia, spiral hyphae
p.52 -

p.53 p.53
Microsporum gypseum , macroconidia
p.53 -

p.54 p.54
Microsporum gypseum , macroconidia
6 or fewer divisions
p.54 -

p.55 p.55
6. Bacterial Culture and Susceptibility
• For those cases where a mixed population of bacteria is seen with cytology
• For those cases that don’t respond to empirical choice of an antibiotic
? Confirm it’s a bacterial infection
? Identify resistant bacteria
• For those cases where therapy may be have side effects, be difficult to administer, or be expensivep.55 -

p.56 p.56
Intact pustule to be sampled
p.56 -

p.57 p.57
Culturette tube
p.57 -

p.58 p.58
Gently cleanse the top of the pustule
p.58 -

p.59 p.59
Open the pustule with a new 25 ga needle
p.59 -

p.60 p.60
Pustule contents wiped onto the culture swab
p.60 -

p.61 p.61
Culture swab into the transport media
p.61 -

p.62 p.62
7. Skin Biopsy
• Cases that should be biopsied
? A patient who is systemically ill
? If there is no response to therapy within 3 weeks
? Any suspected neoplastic disorder
? If there is a persistent ulcer
? If the possible therapy will be expensive, dangerous, or time-consumingp.62 -

p.63 p.63
Anesthesia
• In most cases a local anesthesia can be used
? Epinephrine 1:1000 into the hub of the syringe
? Lidocaine 1 - 2% or bupivacaine 0.25
– 0.5%, 2.5ml
? Sodium bicarbonate 8.4%, 0.25ml
? Use a 25 gauge needle if possible
? 0.5 – 1.0 ml subcutaneously / site• If the animal is intractable or you need to biopsy a sensitive area such as the nasal planum, mucous membrane, pinnae, or foot pad, can sedate or even use general anesthesia
p.63 -

p.64 p.64
Biopsy sampling
• Mark sites with a permanent marker pen
• Minimum of 3 samples; 5 is ideal
• Shave hair if necessary but do not wash
• 6mm disposable punch biopsy; occasionally a 4mm punch
• Elliptical excision of an ulcer or vesiclep.64 -

p.65 p.65
Biopsy sampling
• Gentle removal of the sample
• Blot if necessary
• Site closed with a simple interrupted or cruciate suturep.65 -

p.66 p.66
Biopsy punch
p.66 -

p.67 p.67
Area to biopsy
p.67 -

p.68 p.68
Biopsy site marked
p.68 -

p.69 p.69
Injecting local anesthetic
p.69 -

p.70 p.70
Injecting local anesthetic, close up
Blebp.70 -

p.71 p.71
Using a biopsy punch
p.71 -

p.72 p.72
Using a biopsy punch, close up
p.72 -

p.73 p.73
Removal of the punch
p.73 -

p.74 p.74
Removal of the sample
p.74 -

p.75 p.75
Skin post biopsy
p.75 -

p.76 p.76
Sample submission
p.76 -

p.77 p.77
What to do with the samples
• Preserve in 10% formalin
• Send the samples to a veterinary pathologist with experience with dermatohistopathology
• Best to request a microscopic description
• Give a good history or tentative diagnosis
• Suture removal in 7-10 days and discuss results with the ownerp.77 -

p.78 p.78
8. Intradermal test
• A way to identify relevant allergens for immunotherapy after diagnosing atopic dermatitis
• A way to identify flea allergic dogsp.78 -

p.79 p.79
Intradermal test for atopy – syringes
p.79 -

p.80 p.80
Intradermal test for atopy – shaved
p.80 -

p.81 p.81
Intradermal test for atopy – marked
p.81 -

p.82 p.82
Intradermal test for atopy – injecting
p.82 -

p.83 p.83
Intradermal test for atopy – completed
p.83 -

p.84 p.84
Intradermal test for atopy – indirect light
p.84 -

p.85 p.85
Intradermal test – weak positive reactor
p.85 -

p.86 p.86
Intradermal test – weak positive reactor, close up
p.86 -

p.87 p.87
Intradermal test
p.87 -

p.88 p.88
Intradermal test
p.88 -

p.89 p.89
Intradermal test – indirect light
p.89 -

p.90 p.90
Intradermal test – black dog
p.90 -

p.91 p.91
Intradermal test – flea antigen
p.91 -

p.92 p.92
9. Trichography
• Examination of hair roots
• Examination of hair tips
? Self-induced alopecia
• Examination of hair shaft
? Macromelanosomes in the cortex of color dilute hairs
? Fungal arthrosporesp.92 -

p.93 p.93
Trichography (examination of hairs)
Fractured tip - chewing Tapered tip - normalCourtesy of Dr. Peter Hill
p.93 -

p.94 p.94
Telogen (resting) Anagen (growing)
40X PH VM PH
Courtesy of Drs. Peter Hill, William Millerp.94 -

p.95 p.95
Color Dilution Alopecia
p.95 -

p.96 p.96
Trichography – color dilution alopecia
Clumped melanin / macromelanosome
40X
Courtesy of Dr. William Millerp.96 -

p.97 p.97
Trichography – color dilution alopecia
p.97 -

p.98 p.98
Trichography of fluorescing hair
Arthroconidia
Courtesy of Dr. Tim Nuttallp.98 -

p.99 p.99
Fungal arthrospores
p.99 -

p.100 p.100
DIAGNOSTIC TECHNIQUE
p.100 -

p.101 p.101
QUESTIONS ???
p.101
-
 00:52:03
00:52:03
Diagnostic Approach to the Pruritic Dog
Candace A. Sousa, DVM, Dipl. ABVP, Dipl. ACVDVetScope -
 00:41:15
00:41:15
Diagnostics & Staging
Stacy Santoro Binstock, DVM, DACVIM (Oncology)VetScope -
 00:42:15
00:42:15
To Scope or Not
Amy Allen, DVM, DACVIMVetScope -
 00:49:01
00:49:01
Parasitic Dermatoses of the Dog and Cat
Candace A. Sousa, DVM, Dipl. ABVP, Dipl. ACVDVetScope